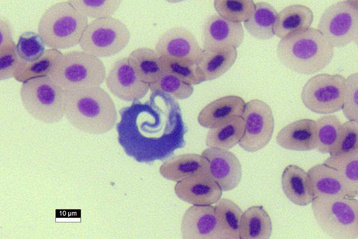

Português
English
de espécies viventes estimadas na Terra
das espécies descritas são parasitos
Esses organismos "invisíveis" aos olhos de muitas pessoas desempenham importante papel nos ecossistemas, porque afetam direta ou indiretamente os indivíduos hospedeiros, suas populações e comunidades.
Estudos sobre a dinâmica das interações permanecem fundamentais e se fazem necessários para o entendimento dos mecanismos envolvidos e efeitos da interação.
O parasitismo pode envolver uma complexa interação de fatores, tais como:

Peixes
Aves
Sapos
Cobras
Lagartos
Jacarés
Tartarugas
Mamíferos Voadores
Mamíferos Não Voadores
Lepidoptera


Protocolos especializados para parasitos de vertebrados

Livros e artigos especializados
Metodologias padronizadas
Acompanhe nas redes sociais e saiba mais sobre a pesquisa em biodiversidade de parasitos